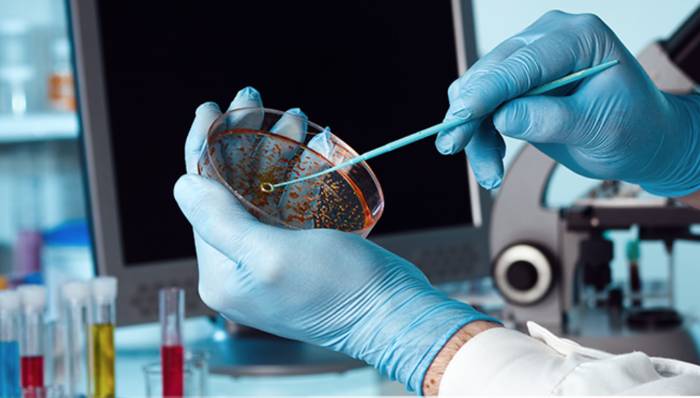

Токсоплазмоз является паразитарной инфекцией, возбудитель – Toxoplasma gondii. Заболевание сопровождается нарушением деятельности центральной нервной системы, патологическим увеличением печени, лимфоузлов и селезенки. Патология не представляет серьезной опасности для человека. Люди болеют, но даже не догадываются об этом. Однако на фоне резкого понижения иммунитета активность паразитов приводит к осложнениям. В группы риска попадают беременные женщины и дети. Анализ на токсоплазмоз подразумевает проведение серологических реакций разными методами. Рассмотрим, как сдавать кровь на токсоплазмоз, какие показатели говорят о норме.
Основные методы диагностики токсоплазмоза
Паразитарное заболевание диагностируется с учетом клинических проявлений и результатов лабораторных и инструментальных методов исследования. За основу берутся серологические реакции.
К сведению, диагностика носит дифференциальный характер. Токсоплазмоз нужно отличить от ряда болезней – мононуклеоз, туберкулез, хламидиоз, герпес и др. бактериальные, вирусные и паразитарные инфекции.
Серологический метод предстает наиболее информативным способом диагностики инфекционных и воспалительных процессов в организме человека. Для исследования берут анализ крови, затем из биологической жидкости получают сыворотку – жидкую часть крови.
В диагностике паразитов используют такие серологические реакции:
- ИФА, РИФ.
- Реакция связывания комплемента. Когда связываются антитела и антигены, то наблюдается прикрепление специфических белковых компонентов, что в свою очередь провоцирует образование иммунного комплекса. Если антитела и антигены не связались друг с другом, то комплемент к ним прикрепиться не может, это говорит об отсутствии комплекса. При токсоплазмозе исследование даст положительный результат.
- Метод Себина-Фельдмана. Суть этой методики заключается в том, что в норме содержимое живых клеток окрашивается в синие цвета. Если же в сыворотке биологической жидкости присутствуют антитела, окрашивание не наблюдается.
Анализ на токсоплазмоз может проводиться посредством аллергического метода. Больному вводят возбудителей внутрикожно. В области введения препарата могут выявляться покраснения и инфильтраты. В зависимости от размера кожного проявления говорят о наличии или отсутствии токсоплазмоза.
Итак, на токсоплазмоз как сдавать кровь, где это можно сделать? Кровь сдают в поликлинике по направлению лечащего доктора либо в частной лаборатории. Исследование требует определенной подготовки. Сдают на голодный желудок, можно пить только воду, но кушать категорически запрещено. За сутки нельзя употреблять алкогольные напитки. Если пациент принимает какие-либо лекарства, то прежде чем сдать анализ крови на токсоплазмоз, необходимо поставить в известность медицинского специалиста.
Исследование иммуноферментным способом на токсоплазмоз – это лабораторная диагностика высокой степени восприимчивости. В ходе обследования обнаруживают антитела, которые называют иммуноглобулинами.
Важно: иммуноферментный анализ крови на токсоплазмоз позволяет выявить антитела класса IgM, IgG, IgA либо антигены определенных инфекционных заболеваний. В результатах указывают не только существование антител, но и их уровень в сыворотке крови.
Для постановки диагноза наиболее важными являются иммуноглобулины IgM, IgG. Они дают информацию не только о наличии паразитарной болезни, но и показывают ее давность:
- Этот иммуноглобулин начинает продуцироваться сразу после инфицирования человека. На 2-3 день его можно обнаружить в биологической жидкости. Если расшифровать анализ на токсоплазмоз, то максимальная концентрация иммуноглобулина наблюдается на 4 неделе болезни;
- IgM выявляется в сывороточной жидкости сразу после заражения, но с течением времени имеет свойство нивелироваться. Если его нашли, то это говорит об остром периоде патологического процесса.
Расшифровка анализа крови должна проводиться медицинским специалистом, поскольку учитывают не только уровень иммуноглобулинов и их наличие, но и авидность к токсоплазмозу.
Часто применяют способ полимеразной цепной реакции (метод ПЦР) на токсоплазмоз, поскольку это особо информативный вариант диагностики. Благодаря методике можно точно выявить ДНК возбудителя в крови. Для проведения исследования используют любой биологический материал – моча, кровь, мокрота, кал, околоплодные воды (при беременности).
В большинстве клинических картин советуется исследовать урину либо кровь. Полимеразная цепная реакция имеет определенные достоинства и минусы. К преимуществам относят точность, низкую вероятность ложноположительного либо ложноотрицательного результата.
Недостатком является относительно высокая стоимость. Помимо этого, такая диагностика требует только качественного оборудования, которое имеется не в каждом медицинском учреждении.
Факт: в большинстве случаев ПЦР – это дополнительный способ диагностики, когда уже была проведена расшифровка анализа на токсоплазмоз методом ИФА и требуется подтвердить либо опровергнуть имеющуюся информацию.
Расшифровка результатов на токсоплазмоз методом полимеразной цепной реакции бывает положительной (+) либо отрицательной (-). В первом случае говорят об инвазии, во втором варианте – о ее отсутствии. Преимущество методики состоит в том, что она выявляет даже ничтожно малое количество паразитирующих микроорганизмов.
Оценка авидности антител
На токсоплазмоз анализ крови предоставляет результаты не только наличия либо отсутствия иммуноглобулинов, но и цифру авидности. Что это такое? Авидность обозначает, что в сданном образце биологической жидкости присутствуют антитела, которые имеют определенное сходство с токсоплазмой.
Чем выше авидность к тосоплазме, тем более специфические иммуноглобулины синтезируются иммунной системой человека. Можно провести сравнение, где антитела это ключ, а антигены являются замком. Так вот, чем больше процент авидности, тем лучше ключик подходит к замку.
В свою очередь, это свидетельствует о том, что иммунитет имел достаточный период времени, чтобы выработать специфические антитела. Анализ на токсоплазмоз характеризуется тремя видами авидности:
- Если показатель меньше 40%, это говорит о малой авидности. Иными словами, молекулы не созрели – после первого контакта с паразитом прошел относительно небольшой период времени. Как правило, в этом случае подозревают острый инфекционный процесс на ранней стадии развития.
- Когда показатель варьируется от 41 до 59% включительно, то говорят о переходной стадии либо серой зоне. Нельзя в полной мере утверждать, что токсоплазмы присутствуют в организме, но и нельзя сказать обратное. Чтобы уточнить предварительный диагноз, проводится еще одно исследование спустя 1-2 недели.
- Более 60% — высокая авидность результатов. Иными словами, иммунитет получил достаточно времени, чтобы ознакомиться с возбудителем патологического процесса, соответственно, успел выработать специфические антитела, ориентированные на его уничтожение.
Стоит знать: авидность свыше 60% — это хроническое носительство либо перенесенное заболевание ранее, что подразумевает стойкий иммунитет. Данный вариант наиболее приемлем в плане прогноза беременности у женщин.
Расшифровка анализов на токсоплазмоз
Итак, какая норма анализа на токсоплазмоз? Постановка диагноза зависит от выявления иммуноглобулинов различного класса. IgG относят к значениям хронической патологии, IgM свидетельствует об острой фазе.
Результаты анализов в норме, когда IgM (-), а IgG (+). Такие показатели диагностируются примерно у 65% населения. Если женщина беременна и были получены такие параметры, то обязательно рекомендуется дополнительное проведение полимеразной цепной реакции, поскольку метод более чувствителен даже к мизерному количеству ДНК возбудителей.
- IgM (-) на фоне IgG (-). Такой результат – человек никогда не болел этой инфекцией, следовательно, стойкого иммунитета к ней нет. Женщина во время беременности с такими показателями попадает в категорию риска. Нужно сдавать кровь каждый триместр, чтобы исключить вероятное заражение и последующие осложнения;
- IgM (+) на фоне IgG (+). Трактовать можно по-разному. Человек болеет в данный момент, либо организм справился с инфекцией, но прошло очень мало времени. IgM с плюсом обычно после выздоровления выявляется еще несколько месяцев, иногда и вовсе в течение одного года. Чтобы уточнить результаты требуется проведение ПЦР, установление процентной авидности;
- IgM (+) на фоне IgG (-) – острый инфекционный процесс. Если пациентка беременна, то высока вероятность внутриутробного заражения. Требуется проведение дополнительной диагностики. При положительном повторном результате назначается медикаментозное лечение.
https://youtube.com/watch?v=pmcl_rgupO8
При выявлении острой фазы токсоплазмоза необходимо провести инструментальную диагностику, поскольку болезнь поражает внутренние органы и системы. Рекомендуется проведение УЗИ органов брюшной полости, для исследования сердечно-сосудистой системы – электрокардиограмма, рентген легких.
Лабораторные исследования – это не окончательный диагноз. Несмотря на высокую достоверность описанных методов, нельзя исключать ложноположительный либо ложноотрицательный результат. Прежде чем поставить диагноз, нужно учесть и др. моменты – жалобы пациента, анамнез, результаты дополнительных медицинских манипуляций.
По статистике, каждый третий житель нашей страны подвергается заражению токсоплазмозом. Часто носители заболевания даже не догадываются о своем состоянии, так как инфекция может никак себя не проявлять – у человека отсутствуют какие-либо выраженные симптомы. По причине несложного, а часто бессимптомного перенесения данного заболевания, диагностике и методам лечения уделяют недостаточное внимание. В то время как в некоторых случаях инфекция может привести к фатальным последствиям и серьезным осложнениям. Что значит, если обнаружен токсоплазмоз в крови? Норма и отклонения показателей, то, каким образом иммуноглобулины групп IgG и IgM способствуют диагностированию заражения, а также как можно справиться и предотвратить заболевание, описано в данной статье.
Что такое токсоплазмоз?
Инфекционное заболевание токсоплазмоз вызывается паразитами. Основными носителями возбудителей являются коты. Но продукты жизнедеятельности животных попадают в почву, откуда могут распространиться на временных носителей: грызунов, коз, коров. С грунтом споры возбудителей могут попасть на овощи. Таким образом, человек может заразиться через немытые руки, особенно после контакта с животными, а также при употреблении недостаточно обработанных мяса и овощей. При попадании паразита в организм развивается токсоплазмоз. Норма антител предполагает в таком случае наличие в результате анализа иммуноглобулина IgM.
Реакция организма на заражение токсоплазмозом
Как и на любую другую инфекцию, организм человека реагирует на заражение токсоплазмозом активизацией иммунных защитных сил. А именно — выработкой специальных антител, иммуноглобулинов белка групп IgG и IgM.
Обнаружив патогенный микроорганизм (антиген), клетки иммунной системы начинают вырабатывать антитела, которые направлены на устранение определенной инфекции. Называют таких помощников в борьбе с заболеванием «иммуноглобулины группы IgG». Находя определенный антиген, они связываются с ним, разрушая структуру. При развитии такого заболевания, как токсоплазмоз, норма в крови IgG — это обнаружение данной группы иммуноглобулинов на третьи сутки после заражения. Сохраняются они в течение всей жизни, защищая человека от вторичного инфицирования. Таким образом, токсоплазмозом можно заразиться лишь один раз, после чего вырабатывается стойкий иммунитет к паразиту – возбудителю заболевания.
При инфицировании токсоплазмозом на помощь организму в борьбе с заболеванием приходят и другие группы иммуноглобулинов, а именно IgM. Обнаружен токсоплазмоз? Норма антител в таком случае — это обнаружение иммуноглобулинов группы IgM в крови непосредственно после попадания паразита в организм. Но иммуноглобулины группы IgM не могут защитить человека от повторного заражения, так как перестают вырабатываться приблизительно спустя 2–4 недели после инфицирования.
Свойства иммуноглобулинов IgG
Стоит более подробно рассмотреть функции и свойства, выполняемые иммуноглобулинами группы IgG в организме при заражении таким заболеванием, как токсоплазмоз. Норма IgG — понятие неоднозначное. Наличие иммуноглобулинов этой группы может указывать как на острую фазу заболевания, так и на длительный процесс. Каким же образом антитела борются с заболеванием? Они выполняют ряд функций, которые защищают организм и неблагоприятно сказываются на жизнеспособности возбудителя заболевания, а именно:
- нейтрализуют токсины, вырабатываемые паразитом;
- участвуют в процессе авидности (связываются с возбудителем);
- стимулируют фагоцитоз;
- имеют свойство проникать через плаценту, формируя тем самым пассивный иммунитет у плода.
Интересным и немаловажным является тот факт, что именно иммуноглобулин группы IgG составляет 80% всех иммуноглобулинов организма. Кроме того, при хронических формах инфекций и аутоиммунных заболеваниях процентное соотношение иммуноглобулинов IgG возрастает.
Расшифровка показателей иммуноглобулина IgG
- Как расшифровать результаты анализа на токсоплазмоз? Норма IgG — это показатели ниже 700 мг/дл. Положительным результатом анализа на измерение количества иммуноглобулинов группы IgG являются показатели 700–1600 мг/дл или 7–16 г/л. Показатели ниже указанных границ считаются отрицательным результатом.
- Используя другие единицы измерения, указывают такие нормы показателей иммуноглобулинов IgG: выше 12 Ед/мл считают положительным результатом, ниже 9 Ед/мл – отрицательным, показатели между указанными нормами являются сомнительными и требуют дополнительных исследований.
Независимо от того, каким образом обозначены показатели анализа на токсоплазмоз, расшифровка результата имеет одинаковое значение. Обнаружен положительный результат на токсоплазмоз в крови? Норма — это наличие антител IgG и отсутствие IgM. Наличие в исследуемом материале иммуноглобулинов IgG говорит о том, что организм встречался с возбудителем токсоплазмоза. Это значит, что человек надежно защищен от вторичного заражения. Но в то же время такие результаты могут свидетельствовать о первичном недавнем заражении. Чтобы подтвердить или опровергнуть данное предположение, необходимо проанализировать показатели иммуноглобулинов группы IgM, которые появляются в организме лишь во время острой фазы заболевания. Соответственно, наличие таких антител говорит о первичном заражении и серьезной опасности для плода. В такой ситуации врач ставит диагноз «токсоплазмоз». Норма в крови — это отсутствие антител группы IgM. Такие показатели свидетельствуют о давнем инфицировании и отсутствии какой-либо опасности для организма.
В случае если результаты анализа говорят об отсутствии иммуноглобулинов IgG в организме, следует придерживаться специальных мер с целью профилактики заражения в период беременности, так как такие результаты свидетельствуют об отсутствии защитных антител от токсоплазмоза.
Методы диагностики токсоплазмоза
Существуют следующие виды диагностики токсоплазмоза:
- Иммунологические и серологические. Они основаны как раз на особенности организма вырабатывать антитела к инфекции. С помощью специальных тест-систем определяют наличие или отсутствие иммуноглобулинов IgG и IgM. Таким образом можно не только обнаружить присутствие защитных антител в организме, но и своевременно диагностировать острую фазу токсоплазмоза. Назначен анализ на токсоплазмоз в крови? Норма — это обнаружение антител IgG и отсутствие IgM.
- Методы непосредственного обнаружения паразита — исследования с помощью микроскопии или ПЦР-диагностики.
- Инструментальные методы применяются только в осложненных и спорных случаях. Применяют УЗИ, компьютерное обследование и другие.
- Биологическая проба также может указать на присутствие в организме иммуноглобулинов группы IgG. После подкожного введения специального аллергенного препарата в течение двух суток наблюдают за реакцией. При появлении отечности регистрируется положительный результат.
Метод диагностики токсоплазмоза ИФА
| Иммуноглобулин IgM | Иммуноглобулин IgG | Характеристика показателей |
| — | — | Следует уделить особое внимание профилактическим мерам. Такие результаты указывают на отсутствие защитных антител в организме человека. |
| — | + | Результат говорит о давнем инфицировании, не представляющем опасности для организма. Кроме того, человек защищен от повторного заражения токсоплазмозом. |
| + | — | Такой вариант показателей самый неблагоприятный. Он свидетельствует о первичном заражении, которое произошло менее 5 дней назад. |
| + | + | Также является негативным результатом, так как говорит о заражении не позднее месяца назад. |
Токсоплазмоз: норма в крови при беременности
Такое на первый взгляд неопасное заболевание, как токсоплазмоз, может проявиться серьезными осложнениями у людей с ослабленным иммунитетом. Но особую опасность заболевание представляет для беременной женщины и ее плода, так как паразит может проникать через плаценту и заражать нерожденного малыша. Несформированный иммунитет крохи не способен противостоять возбудителю, и во многих случаях ребенок погибает. Стоит отметить, что при инфицировании беременной женщины на ранних сроках велика вероятность выкидыша, замирания плода, образования патологий, не совместимых с жизнью.
Инфицирование на поздних сроках приводит к преждевременным родам, мертворождению, появлению ребенка с серьезными патологиями развития, такими как:
- воспаление сетчатки глаза, слепота;
- глухота;
- увеличение селезенки и печени;
- нарушение развития внутренних органов;
- желтуха;
- поражение центральной нервной системы (судороги, паралич, гидроцефалия, олигофрения, эпилепсия, энцефалит);
- пневмония;
- нарушение работы сердца;
- внешние уродства: расщепление губ и неба, патологии развития конечностей, грыжи, гермафродитизм, косоглазие, катаракты и другое.
Многие из вышеперечисленных врожденных патологий приводят к детской смертности в течение нескольких первых недель жизни или к глубокой инвалидности. Встречаются случаи рождения ребенка без выраженных, на первый взгляд, патологий. Но в течение первого года жизни появляются симптомы острого токсоплазмоза.
Учитывая высокий уровень опасности инфекции для нерожденного малыша, врачи в период планирования, зачатия, а также на протяжении всей беременности назначают женщинам комплексный анализ на ТОРЧ-инфекции, в который входит исследование на токсоплазмоз. Норма анализов при беременности ничем не отличается от общепринятых показателей.
Своевременное лечение значительно повышает шансы рождения здорового малыша. В данном случае польза от применяемых лекарств превышает возможный нанесенный ими вред.
Показания к лечению токсоплазмоза
- при остром токсоплазмозе с целью профилактики серьезных осложнений у больных СПИДом и беременных женщин;
- при хронической форме заболевания в период обострения с целью формирования нормального иммунного ответа;
- лечение может быть назначено при хроническом токсоплазмозе в случае развития хориоретинита, бесплодия, невынашивания беременности.
Лечение токсоплазмоза у людей с ослабленным иммунитетом при отсутствии беременности
Людям с ослабленным иммунитетом могут быть назначены разные препараты, в зависимости от симптоматики и анамнеза:
Беременным женщинам терапия вышеуказанными препаратами запрещена.
Лечение токсоплазмоза у беременных
Как расшифровать у будущей мамы анализ на токсоплазмоз? Норма при беременности определяется также: наличием или отсутствием паразита-возбудителя или защитных антител групп Igg и IgM.
Если анализ подтвердил наличие острой фазы инфицирования, может быть использована одна из двух видов терапии:
Методы профилактики
Если вы планируете малыша, а результаты анализов показали отсутствие антител к токсоплазмозу, нет никакого другого способа защитить будущего малыша от заболевания, кроме профилактических мер. Опираясь на знания о способах заражения, можно обозначить следующие профилактические мероприятия:
- свести к минимуму контакт с животными на протяжении всего периода беременности;
- не употреблять сырое и плохо прожаренное мясо, немытые овощи;
- работать с грунтом только в резиновых перчатках;
- не забывать тщательно и часто мыть руки.
Такие несложные правила помогут сохранить не только здоровье, но и жизнь нерожденному малышу и будущей маме.
Опираясь на информацию, изложенную в статье, можно сделать вывод, что токсоплазмоз – это крайне опасное заболевание для будущей мамы и ее малыша. Но современная медицина в состоянии своевременно обнаружить специфические антитела, которые защищают организм от инфекции. При этом необходимо не только вовремя сдать, но и правильно интерпретировать результаты анализа на токсоплазмоз. Норма у беременных ничем не отличается от общеустановленных показателей. Так, наличие или отсутствие иммуноглобулинов IgG может свидетельствовать о прямо противоположных клинических картинах. Поэтому доверьтесь специалисту – строго выполняйте все его рекомендации, не занимайтесь самостоятельной расшифровкой результатов. В таком случае вероятность благополучного рождения здорового ребенка очень высока. Будьте здоровы!
Токсоплазмоз — паразитарная инфекция, которая способна поражать организм человека и животных. Возбудитель — Toxoplasma gondii. Патология широко распространена во всем мире. Пик заболеваемости наблюдается в Южной Америке и Африке — около 90% населения. В Европе и Северной Америке этот показатель несколько ниже, но все равно высокий — от 30 до 50%. Особенность болезни — бессимптомное течение в части случаев и клинические формы, которые сопровождаются пестрой клинической картиной с различными симптомами.
Токсоплазмоз бывает острым и хроническим. Если произошла хронизация процесса, симптомы проявляются достаточно вяло или вообще отсутствуют. Различают также врожденный и приобретенный процесс. Заболевание может передаваться от матери к ребенку и поражает плод во время внутриутробного развития. Такое заражение может привести к гибели эмбриона или развитию тяжелых пороков, ведь возбудитель влияет на системы и органы, которые только формируются. Приобретенная форма поражает внутренний органы, нервную систему.
Главный источник заражения — домашние животные, преимущественно, кошки. Особенно опасно общение с ними для беременных женщин. Есть и промежуточные хозяева токсоплазмы, другие животные, в которых возбудитель находится в форме цист. Контакт с ними не приводит к заражению. А вот употребление мяса в пищу — да. Это касается свинины, баранины. Это еще один способ инфицирования. Возбудитель не погибает, если продукты не проходят должную обработку температурой. Известны случаи передачи инфекции насекомыми, которые прокусывают кожу и сосут кровь.
Риск заражения повышают такие факторы:
пренебрежение правилами гигиены;
контакт с экскрементами зараженного животного;
несоблюдение техники приготовления продуктов животного происхождения.
Изначально патология протекает бессимптомно. Первые признаки патологии могут появиться спустя несколько месяцев или даже лет после заражения.
У новорожденных распознать врожденную инфекцию можно по таким признакам:
желтушность кожных покровов;
сниженное количество тромбоцитов;
макулопапулезная сыпь на коже.
Инкубационный период заболевания длится около 2-3 недель. За это время у большинства пациентов вырабатываются антитела — специфические вещества, направленные на борьбу с возбудителем.
Острый токсоплазмоз напоминает поражение головного мозга и его оболочек. Наблюдается головная боль, тошнота, общая слабость, возможны судороги, появляется напряжение мышц затылка и пациент не может согнуть шею. Далее происходит поражение зрительного нерва, ухудшается зрение.
После этого может возникнуть миокардит. Это воспаление мышечной ткани сердца. Орган перестает нормально выполнять свою функцию, наблюдается острая боль в грудной клетке, перебои работы, нарушение ритма. Человек ощущает слабость, возможны потери сознания. Опасность миокардита заключается в том, что те ткани, которые были воспалены, могут замещаться рубцовым веществом. Состояние называется кардиосклерозом и является необратимым процессом.
Поражение пищеварительных органов сопровождается сухостью во рту, тупой болью в животе, вздутием, нарушением отхождения газов из кишечника. Снижается аппетит, может нарушаться стул.
Заболевание поражает работу эндокринных желез. Это отражается в нарушении менструального цикла, у мужчин снижается сексуальная функция, нарушается работа поджелудочной железы. Опасное осложнение болезни — привычное невынашивание беременности, которое может остаться у женщины на длительный срок.
Осложнениями со стороны глаз являются увеиты, хориоретиниты, близорукость.
Со стороны опорно-двигательного аппарата наблюдаются такие изменения, как боль в мышцах. Особенно беспокоит голень, бедро, поясница, мышцы шеи и рук. Боль возникает настолько резко и остро, что пациент перестает двигаться на некоторое время.
Из общих симптомов стоит отметить головную боль, высокую температуру, общую слабость, озноб. Происходит реактивное увеличение печени и селезенки, воспаляются лимфатические узлы, болят суставы и мышцы.
Хроническое течение сопровождается менее насыщенно клиникой, может быть бессимптомным. Температура если повышается, то совсем незначительно. Беспокоит тупая головная боль, слабость, может нарушаться память и умственная деятельность.
При обострении хронического процесса беспокоит озноб, лимфаденопатия. Осложнения затрагивают нервную систему, зрение. На фоне токсоплазмоза может возникать поражение организма другими инфекциями.
Как видим, болезнь или не имеет симптомов, что делает невозможным своевременную постановку диагноза, или имеет столько разных признаков, что сложно провести дифференциальную диагностику.
Диагностика токсоплазмоза показана в таких случаях:
скрининг в период планирования беременности и во время вынашивания плода;
появление лимфаденопатии неясного генеза у тех беременных женщин, кто ранее не болел или не проходил диагностику;
фетоплацентарная недостаточность и другие признаки внутриутробной инфекции;
возникновение энцефалита или менингита у пациентов с иммунодефицитом, онкологической патологией, на фоне приема цитостатиков или химиотерапии;
увеличение и болезненность лимфатических узлов;
увеличение в размерах печени и селезенки;
повышение температуры без явных причин;
признаки врожденного токсоплазмоза у ребенка.
На сегодняшний день постановка диагноза “токсоплазмоз” происходит на основе данных таких исследований:
Серологический метод (ИФА);
Каждый метод имеет свои особенные показания к применению. Рассмотрим их подробнее.
Серологический метод (ИФА)
Это иммунологическое исследование, в основе которого лежит реакция “антиген-антитело”. Метод позволяет оценить качественные и количественные показатели возбудителя в крови. Реакция происходит благодаря специфическим реактивам, которые добавляют к сыворотке крови пациента. Если антитела ихз крови реагируют на антиген, который есть в реактиве, значит диагноз можно считать подтвержденным. Методика широко распространена, используется для подтверждения клинических признаков токсоплазмоза.
Реакция иммунофлюоресценции основана на свойстве иммунных комплексов подсвечиваться иммунофлюоресцентным веществом. Если реакция происходит, медицинский работник видит специфическое свечение, оценивает его интенсивность и количественные показатели. Можно оценить поверхностные и внутриклеточные антигены. Метод входит в экспресс-диагностику, не занимает много времени и часто используется для постановки диагноза. Обязательным условием является специфическое оснащение лаборатории и навыки персонала.
Метод непрямой иммунофлюоресценции используется не так часто. Он позволяет определить тип антител в различных титрах сыворотки крови. Иммуноглобулины типа М говорят об острой стадии процесса, а антитела класса G — признак хронического течения или ранее перенесенного заболевания. Следует качественно проводить диагностику, ведь использование низких титров легко принять за ложноположительный результат.
Суть исследования заключается в непосредственном обнаружении возбудителя в биологическом материале. Для этого проводится исследование крови, слюны, спинномозговой жидкости, биоптатов. Обнаружить микроорганизмы можно с помощью специального окрашивания. Метод имеет неоднозначную оценку. С одной стороны, можно подтвердить наличие возбудителя, но сказать, как давно пациент болеет, в какой стадии процесс — сложно. К тому же, отсутствие паразитов в исследуемом материале не всегда говорит о том, что пациент не болен токсоплазмозом.
К сожалению, полностью устранить паразита из организма очень сложно. Токсоплазмы образуют цисты, в которых могут сохраняться в тканях длительное время. Они устойчивы к медикаментам. Особенно интенсивного лечения требуют пациенты с скомпрометированным иммунным статусом.
Методы профилактики заключаются в следующем:
соблюдение гигиенических правил;
полноценная кулинарная обработка продуктов животного происхождения;
своевременная диагностика домашних животных.
Лаборатория центра оснащена новейшим диагностическим оборудованием. Анализы выполняются быстро и качественно. В штате медицинских центров работают высококвалифицированные специалисты, что позволяет сделать диагностику разносторонней и эффективной. Пациент может не только установить факт заболевания, но и пройти расширенную проверку организма, а также лечение. Для наших врачей нет заболевания отдельной системы — они оценивают полноценное состояние пациента и лечат его, а не патологию. Есть возможность получить результаты исследования на личную электронную почту или получить их в распечатанном виде в медицинском центре.
Лаборатория АО «СЗЦДМ» предлагает услуги, обеспечивающие комплексное и преемственное лабораторное обследование пациента Диагностика В медицинских центрах АО «СЗЦДМ» проводят качественные диагностические исследования всего организма Лечение Наши медицинские центры ориентированы на обслуживание пациентов в амбулаторном режиме и объединены единым подходом к обследованию и лечению пациентов. Реабилитация Реабилитация — это действия, направленные на всестороннюю помощь больному человеку или инвалиду для достижения им максимально возможной полноценности, в том числе и социальной или экономической. Выезд на дом Внимание! Действует акция «Выезд на дом — 0 рублей» Профосмотры АО «СЗЦДМ» проводит профилактические осмотры работников, которые включают в себя — комплексы лечебных и профилактических мероприятий, проводимых для выявления отклонений в состоянии здоровья, профилактики развития и распространения заболеваний.
Читайте также: